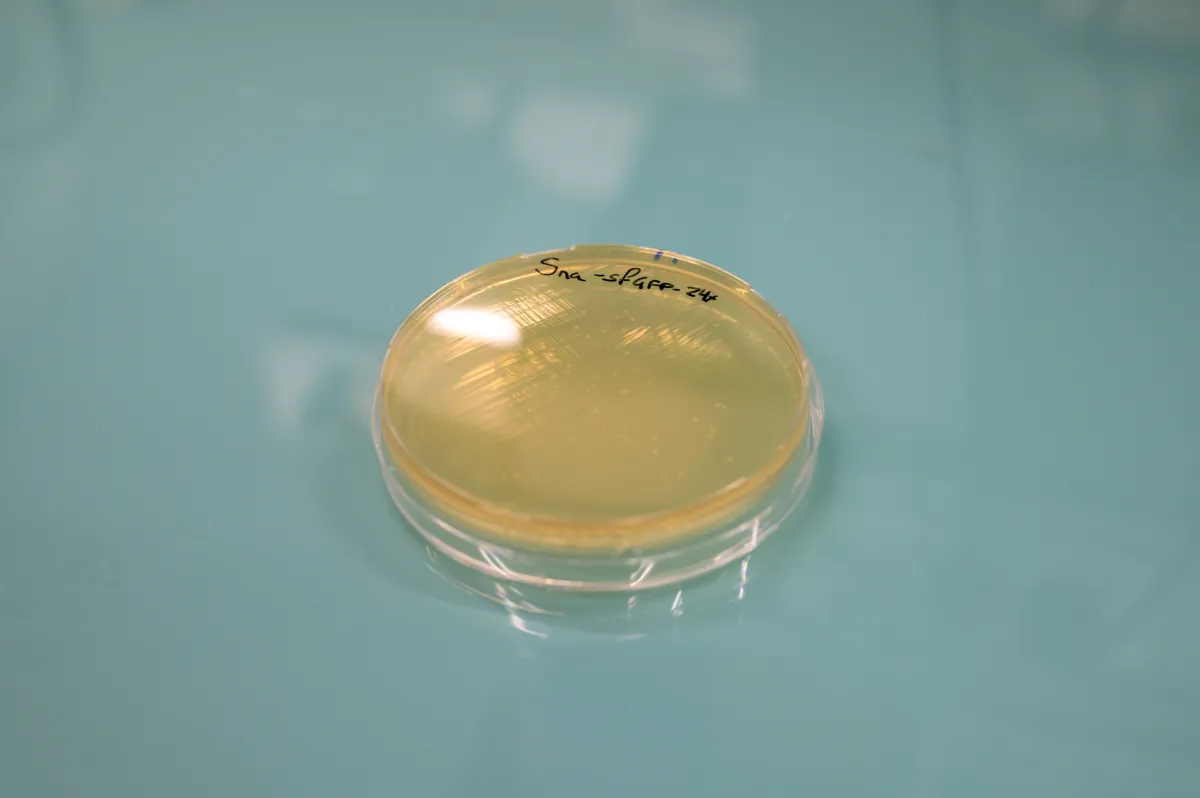

Mounia Lagha Studying gene expression in early development
Mounia Lagha, CNRS research director, head of the transcription regulation during development team at the Institute of Molecular Genetics in Montpellier (France).
- 2021 • Bettencourt Prize Coups d'Élan pour la recherche française



The 2021 Bettencourt Prize Coups d'élan pour la recherche française went to developmental biology researcher Mounia Lagha for her work on embryonic development.
Gene expression in development: being in the right place at the right time
During embryonic development, perfect coordination is necessary for the correct positioning of tissues and organs. This is often attributed to gene expression at a specific time: when a gene must be transcribed into messenger RNA and translated into protein. But Dr. Lagha believes this falls short in explaining the fascinating complexity of development. She and her team are about to add a new variable to the equation: the location in the cell where protein production takes place.
In her Montpellier laboratory, Dr. Lagha uses fruit flies to study gene expression during the first hours of development. At that stage, the embryo has a very simple structure (only one layer of nuclei) and develops so fast that genetic expression in a whole living organism can be monitored in real time.
The foundation’s support
The Bettencourt Prize to Boost French Research will allow Dr. Lagha’s team to use a state-of-the-art light sheet microscope that will let them view newly synthesized messenger RNA and proteins in a living embryo at the single molecule level in real time.
This technology will also allow them to know where in the cell certain messenger RNAs are preferentially translated into proteins, thus demonstrating how the time and place of translation is important for an embryo’s harmonious development.
Mounia Lagha in a few words
Mounia Lagha is an agricultural engineer specializing in transcriptional regulation and development. For her PhD at the Pasteur Institute in Paris, she studied muscle tissue development in mice. During her post-doctorate at UC Berkeley, where she moved in 2010 to work on polymerase II, the enzyme that carries out gene transcription, she took the fruit fly embryo as her research model. In 2015, she became a team leader at the Institute of Molecular Genetics in Montpellier.
In her regulation of gene expression during development laboratory, she develops cutting-edge techniques to observe and quantify the transcription and translation of key genes in the developmental pattern of fruit fly embryos. They allow her to study events lasting a second and to understand the identity of each cell in this fascinating, complex process.

Bettencourt Prize Coups d'Élan pour la recherche française
The Bettencourt Prize Coups d'Élan pour la recherche française was created by the Foundation in 2000. It has rewarded 78 French laboratories and more than 900 researchers have benefited from this prize. Until 2021, this prize was awarded each year to four research teams, from Inserm and the CNRS Institute of Biological Sciences. The amount of the prize endowment was 250,000 euros per laboratory.
All the award-winners